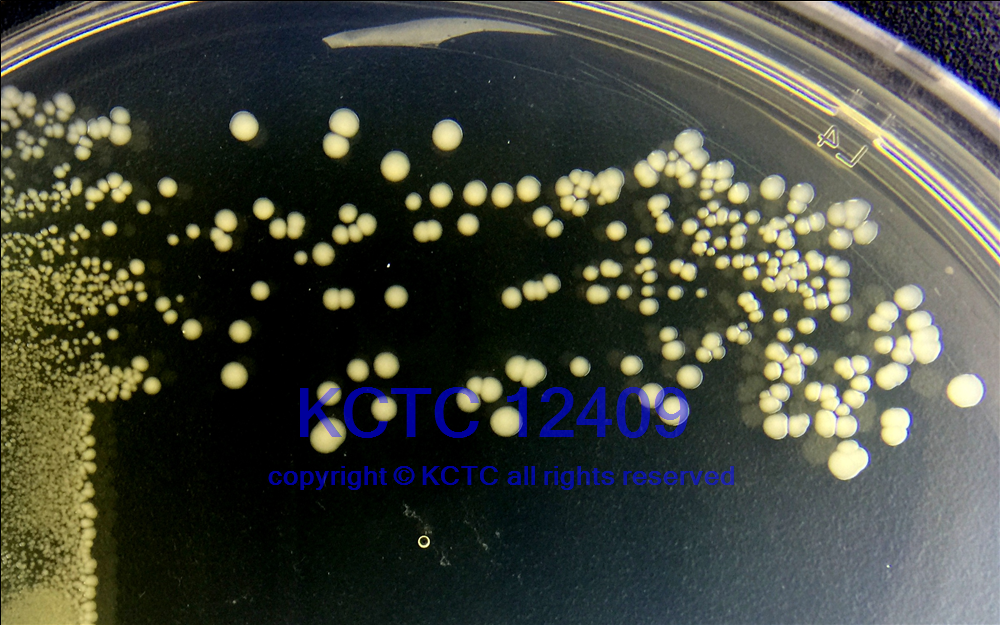

KCTC No. 12409
(KCTC Other No.)
Resource Type Bacteria
Name Acinetobacter schindleri
Type Strain Yes
Biosafty Level 2
LMO No
Synonym
Phylum (ex Phylum) Pseudomonadota (Proteobacteria - Gammaproteobacteria)
Genome Information
NCBI Genome UID : GCA_000368625.1
JGI Genome ID : Gp0034060
History <- CCUG <- .Dijkshoorn, LUMC, Leiden, Netherlands 21 Aug 2001 <- A.Nemec
Source From Human, urine, Pribram, Czech Republic [4922]
Other Collection No. CCUG [45560], CIP [107287], DSM [16038], LMG [19576], CNCTC [6736], LUH [5832]
Reference 4922
KCTC Media No. KCTC media No. 98 Tryptic Soy Agar
KCTC media No. 1 Nutrient Agar
Oxygen Requirement Aerobic
Temperature 30 ℃
pH netural pH ?? ?? (???? ??)
KCTC12409